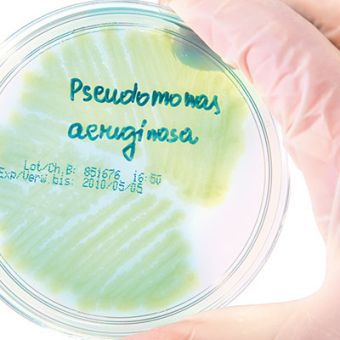
Le Pseudomonas aeruginosa

L'eau est un élément indispensable au fonctionnement des établissements de santé et/ou recevant du public (ERP), mais représente aussi une source ou un vecteur de nombreuses maladies notamment pour les personnes les plus vulnérables.
La prévention des risques sanitaires liés aux microorganismes hydriques dans les réseaux d'eau chaude sanitaire (ECS) doit être une préoccupation constante des responsables d'établissements.